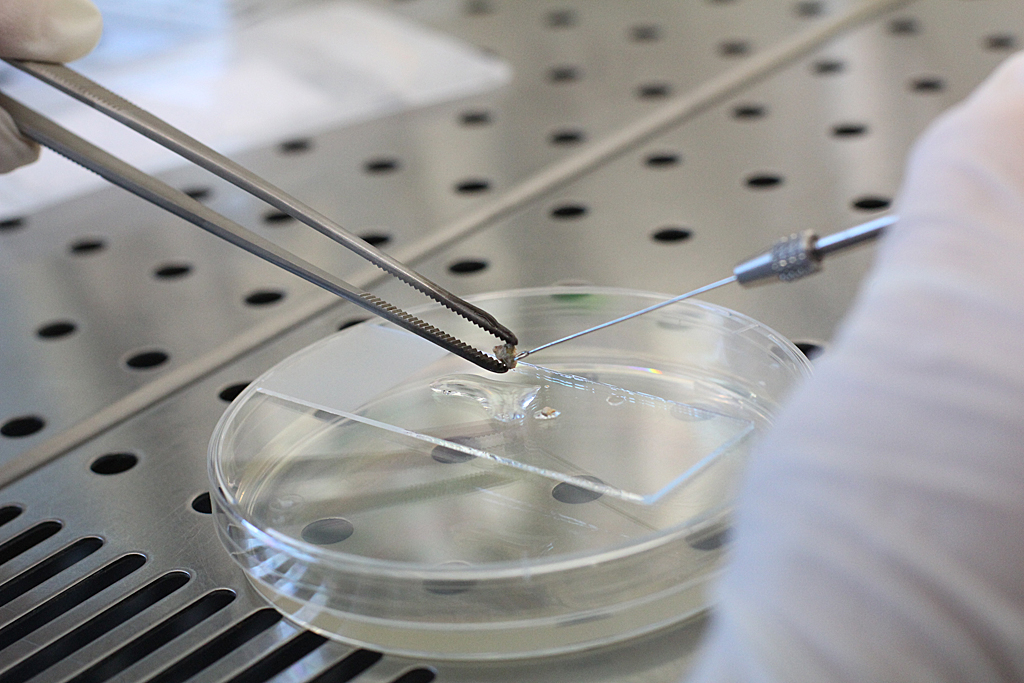

Řešení pro líhně plísní a řas pod zateplenými fasádami
12. 2. 2019
CxI ve spolupráci s firmou Prahotherm, servis fasád s.r.o. vyvíjejí metodu účinné detekce mikroorganismů a jejich eliminace. V současné době dokážeme určit, co na fasádě žije a jaký vliv to může mít na lidské zdraví.
Nejčastěji se jedná o řasu Apatococcus sp., nebo plíseň Cladosporium. Kromě nevalného vzhledu, mohou mikroorganismy fasádu degradovat a některé z nich produkují mykotoxiny, které mohou přímo ohrožovat lidské zdraví. Ty se do bytu dostávají při větrání a způsobují záněty očních rohovek, alergie a další zdravotní komplikace. Kolonizace, v závislosti na velkém množství faktorů, jako jsou blízkost ke stromům, kvalita omítky či návrh klempířských prvků, je otázka 7-10 let.
Praktickým řešením tohoto problému jsou nátěrové hmoty, které CxI ve spolupráci s partnery vyvinul před dvěma lety. Nyní se zkouší roztoky s nanočásticemi stříbra o kterém je známo, že má antibakteriální účinky.
Celý článek na T-UNI

.jpeg)

.jpeg)
.png)


.jpeg)
.png)
.png)
